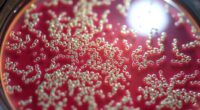
antibiotic resistance crisis 2025

In antiquity, Greeks approached myths with a questioning mindset, challenging legends and seeking natural explanations. Instead of accepting stories about gods and supernatural forces at face value, they examined phenomena like storms and eclipses through reason and observation. Thinkers like Thales and Anaxagoras explained events without divine intervention, laying the groundwork for scientific thinking. If you want to discover how these ancient skeptics transformed myths into rational ideas, explore the clever ways they explained away legends.
Key Takeaways
- Greeks employed historical skepticism, questioning the factual accuracy of myths and legends.
- They sought natural, rational explanations for phenomena traditionally attributed to gods.
- Thinkers like Thales and Anaxagoras explained events like eclipses through scientific causes.
- The shift from divine to natural explanations fostered critical thinking and scientific inquiry.
- Myths were reinterpreted as cultural narratives rather than literal truths, promoting rational understanding.

Have you ever wondered how ancient societies distinguished fact from fiction? Back in Greece, people faced the challenge of separating myth from reality without the benefit of modern science. They often relied on a mindset rooted in historical skepticism, questioning stories that seemed too fantastical or inconsistent with what they observed. Instead of accepting legends at face value, Greek thinkers and scholars sought rational explanations for phenomena that others might have attributed to gods or supernatural forces. This approach was *essential* in moving from superstition toward a more logical understanding of the world around them.
For the Greeks, myths served more than just entertainment; they were cultural narratives woven into their identity. However, many Greek philosophers and historians recognized the importance of scrutinizing these stories critically. They asked questions like, “Is this really how things happened?” or “Could there be a natural explanation for this event?” This questioning process was an early form of skepticism, one that challenged the literal truth of myths while still respecting their cultural significance. They didn’t dismiss these stories outright but sought to interpret them through rational explanations that aligned with observable facts.
One notable example of myth busting in ancient Greece is the effort to explain natural disasters and celestial phenomena without invoking divine intervention. Instead of believing that storms or eclipses were punishments from gods, thinkers like Thales and Anaxagoras proposed natural causes. They looked for scientific reasons behind these events, laying the groundwork for rational explanations that would eventually evolve into scientific inquiry. By doing so, they demonstrated a critical mindset—questioning accepted narratives and searching for logical, evidence-based answers.
This rational approach was not universally accepted overnight, but it marked an important shift in how the Greeks viewed their world. They moved from a worldview dominated by gods and mythic stories to one where natural laws and human reason played a central role. While they often still believed in divine beings, they were increasingly open to the idea that many phenomena could be explained through observation, reason, and evidence. This attitude fostered a tradition of intellectual curiosity and skepticism that would influence later scientific and philosophical developments.
In essence, the Greeks’ method of myth busting combined a healthy dose of skepticism with a desire to understand the world rationally. They didn’t just accept stories as facts; they challenged them, scrutinized them, and looked for logical explanations. This approach helped transform myth into a cultural framework rather than a literal account of reality and laid the foundation for rational inquiry that continues to shape our understanding today. Moreover, their emphasis on empirical observation and logical reasoning laid the groundwork for the development of scientific methodologies that are still in use today.

Ancient Greek Philosophers (Leather-bound Classics)
As an affiliate, we earn on qualifying purchases.
As an affiliate, we earn on qualifying purchases.
Frequently Asked Questions
How Did Ancient Greeks Differentiate Between Myth and History?
You can differentiate between myth and history by applying historical skepticism and myth verification. The ancient Greeks often examined sources critically, questioning their accuracy and consistency. They distinguished history through factual accounts supported by evidence, while myths were seen as symbolic stories explaining origins or beliefs. By verifying details and considering context, you recognize that myths often served cultural or religious purposes rather than providing literal historical truth.
What Sources Did Greeks Use to Debunk Legends?
Imagine you’re in ancient Greece, where you rely on historical records and philosophical debates to debunk legends. You scrutinize written texts, compare different accounts, and engage thinkers like Thales or Socrates, who question supernatural tales. These sources and discussions help you distinguish myth from reality, encouraging critical thinking. By analyzing evidence and engaging in dialogue, you actively challenge legends, turning ancient stories into rational explanations rather than unquestioned truths.
Were Myth-Busting Methods Consistent Across Greek City-States?
You’ll find that myth-busting methods weren’t entirely consistent across Greek city-states. Some relied more on faith versus reason, emphasizing storytelling techniques that reinforced tradition, while others promoted rational explanations rooted in philosophy. These differences reflect regional attitudes toward legends, with certain places skeptical of supernatural tales and others embracing them as cultural truths. So, your approach to debunking myths varied depending on local beliefs, arguments, and storytelling methods.
How Did Greek Mythology Influence Their Scientific Explanations?
Greek mythology shaped their scientific reasoning by inspiring philosophical inquiry that sought natural explanations for phenomena. You see, they moved beyond legends, questioning gods’ roles and observing the world around them. This curiosity led thinkers like Aristotle to develop methods based on evidence and logical thinking. Their mythology, consequently, didn’t just serve stories but also sparked a mindset that laid the groundwork for scientific exploration.
Did Myth-Busting Evolve Over Different Periods in Greek History?
Yes, myth-busting evolved over Greek history. You see, as rational inquiry and myth skepticism gained prominence, especially during the Classical period, Greeks started questioning traditional legends. They began seeking natural explanations for phenomena, moving away from literal myth interpretations. This shift marked a change from purely mythological views to more analytical approaches, laying groundwork for scientific thinking that would influence later civilizations.

LINKTOR Chemistry Molecular Model Kit (444 Pieces), Student or Teacher Set for Organic and Inorganic Chemistry Learning, Motivate Enthusiasm for Learning and Raising Space Imagination, A Fullerene Set
FOR BASIC TEACHING TO ADVANCED SCIENCE: 444 pieces molecular model kit, including 136 atoms, 158 bonds and 150…
As an affiliate, we earn on qualifying purchases.
As an affiliate, we earn on qualifying purchases.
Conclusion
As you uncover how the Greeks explained their legends, you realize it’s more than just myth-busting—it’s a glimpse into their curious minds. But what if some stories weren’t just attempts to explain, but secrets waiting to be uncovered? Stay tuned, because beneath their rationalizations lie mysteries that could change everything you thought you knew about ancient beliefs. The real story, it seems, might still be hidden just beyond the horizon.
historical skepticism educational toys
As an affiliate, we earn on qualifying purchases.
As an affiliate, we earn on qualifying purchases.

Greek Coloring Book Myths and History: Explore Ancient Greek Mythology and History Through Art and Imagination
As an affiliate, we earn on qualifying purchases.
As an affiliate, we earn on qualifying purchases.